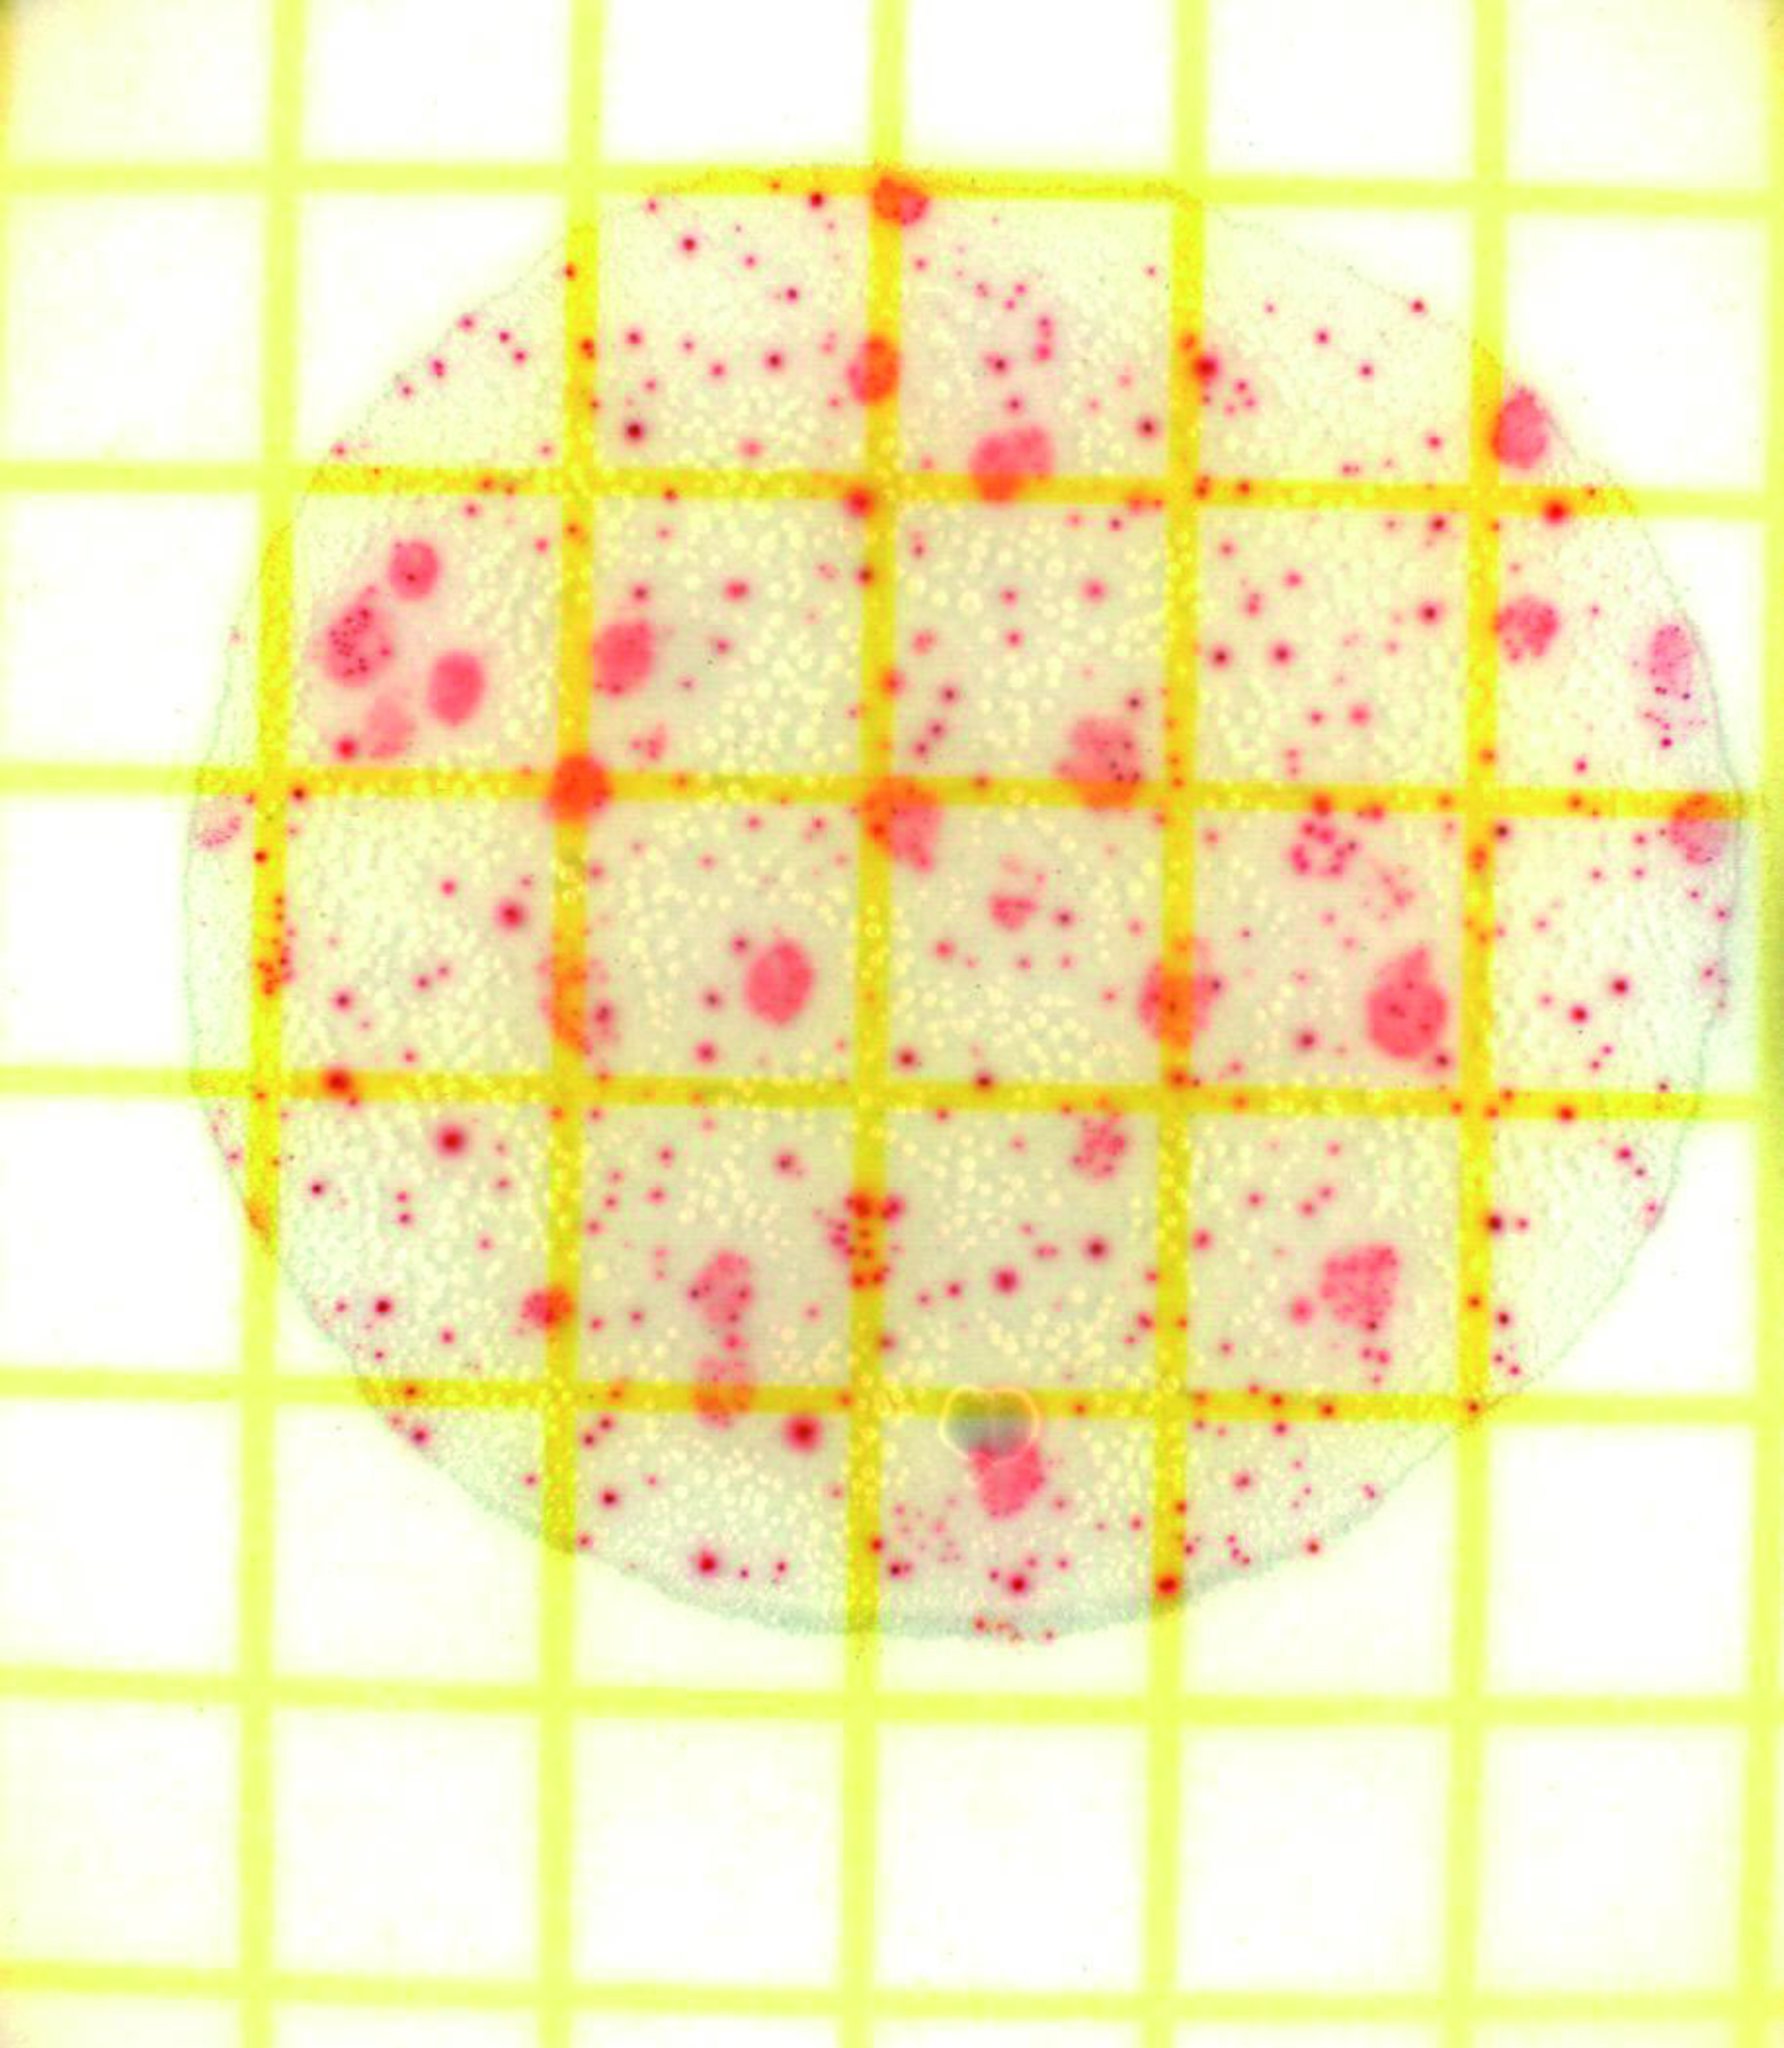

мч в воздухе
Омч в воздухе 110 фотографий
13.07 2009
Почему не пришел qr
Мотилак инструкция для детей
1с как отключить регламентные задания
Билирубин как пишется в анализах
Даклатасвир форум
Малыши с карими глазами
Критерии баллов огэ математика 2026
Пион colonel owen cousins
Варго новейшее